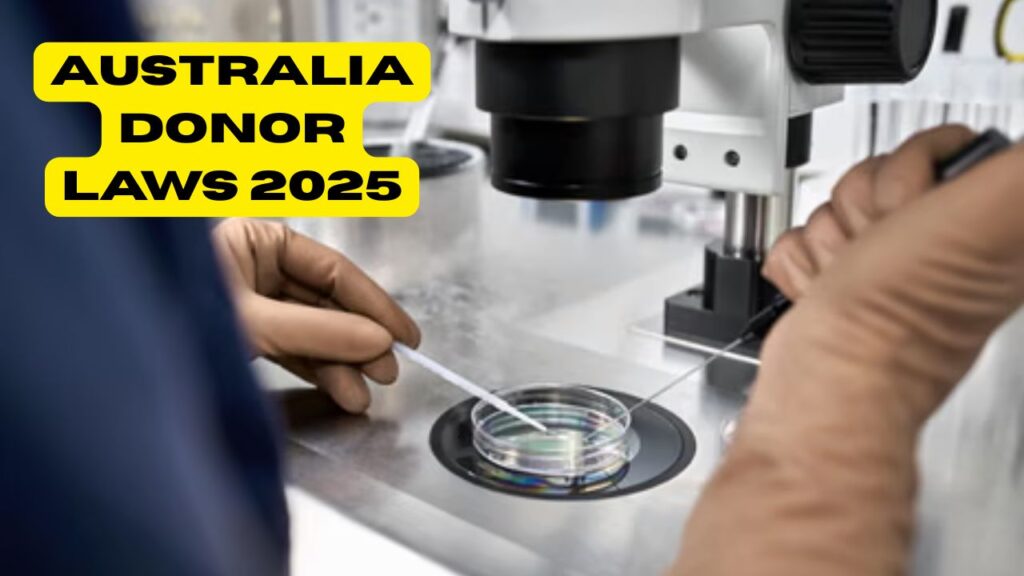
Donor Conception Laws in Australia 2025

Donor Conception Laws in Australia 2025 – Donor conception laws in Australia have evolved significantly in recent years, ensuring better protection, transparency, and rights for donor-conceived individuals, parents, and donors. As of 2025, Australian states continue to refine their policies to create consistent national standards that prioritise the identity and welfare of donor-conceived children. These laws not only regulate sperm, egg, and embryo donations but also address the crucial issue of access to donor information. This article explains the key legal aspects of donor conception in Australia 2025 and what every parent, donor, and recipient should know.
Updated Donor Conception Laws for Australian Citizens
In 2025, Australian citizens have access to improved donor conception laws that provide greater transparency and accountability within the fertility industry. The recent legal changes ensure that donor-conceived people can access identifying information about their donors once they turn 18. Many states, such as Victoria and New South Wales, have already implemented donor registers and are aligning their frameworks for national consistency. These reforms also place stricter limits on the number of families a donor can assist, helping to protect genetic diversity and prevent accidental relatedness among donor offspring across Australia.
Parental Rights and Donor Identification Rules in Australia
For intended parents and donors, understanding donor identification rules is crucial under Australian reproductive law. As of 2025, anonymous donations are no longer permitted anywhere in the country. Each donor’s identity must be recorded by licensed fertility clinics and reported to a state or national donor registry. Parents using donor conception services must be informed of their child’s rights to access identifying information in the future. This shift towards transparency supports both the psychological well-being of donor-conceived individuals and the integrity of assisted reproductive technology (ART) programs in Australia.
| State/Territory | Key Law/Authority | Donor Anonymity | Registry Access Age | Max Families per Donor |
|---|---|---|---|---|
| Victoria | Victorian Assisted Reproductive Treatment Act | Not Allowed | 18 Years | 10 Families |
| New South Wales | Assisted Reproductive Technology Act | Not Allowed | 18 Years | 5 Families |
| Queensland | Human Reproductive Technology Regulations | Not Allowed | 18 Years | 10 Families |
| Western Australia | Reproductive Technology Council | Not Allowed | 18 Years | 5 Families |
| Tasmania & ACT | State ART Guidelines | Not Allowed | 18 Years | 5–10 Families |
Donor Record Access and Fertility Regulations Across Australia
Access to donor records and fertility regulations across Australia are designed to balance privacy with the right to identity. In 2025, donor-conceived people can now apply directly through their state’s donor registry to learn identifying and non-identifying details about their biological donors. Donors, too, have the option to receive non-identifying updates about offspring numbers and health outcomes. Fertility clinics are required to maintain accurate records for a minimum of 75 years, ensuring that data is preserved for future generations. These measures highlight Australia’s commitment to ethical and transparent reproductive practices.
Legal Obligations for Donor Clinics in Australian Territories
Donor clinics in Australian territories must adhere to strict compliance under the Assisted Reproductive Treatment (ART) guidelines. These include mandatory counselling for all parties, detailed consent procedures, and accurate submission of data to donor registers. In 2025, the Australian government has emphasised nationwide cooperation among fertility authorities to close regulatory gaps and ensure consistent donor protection standards. Clinics found in violation of these laws can face penalties, licence suspensions, or closure. For parents and donors alike, working with accredited clinics is the safest way to ensure lawful and ethical donor conception practices.
Frequently Asked Questions (FAQs)
1. Is anonymous sperm or egg donation still allowed in Australia?
No, anonymous donation is no longer permitted anywhere in Australia as of 2025.
2. At what age can donor-conceived individuals access donor information?
Donor-conceived individuals can generally access identifying information at the age of 18.
3. Are there limits on how many families a donor can help?
Yes, most states limit donors to helping between five and ten families to ensure genetic safety.
4. Do all states in Australia follow the same donor conception laws?
Not entirely; each state regulates independently, but efforts are ongoing to create national consistency by 2025.




